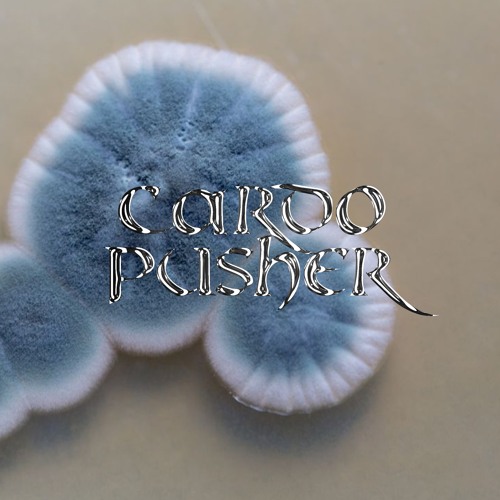

If you’re currently lucky to be in a position to spare some funds, please consider making a charitable donation in your community to help fight the Covid-19 outbreak. Should you still have any additional good fortune left, we have put together an Aid EP, to help support the artists on our label, currently under financial pressure due to the massive amount of event and DJ gig cancellations – and to keep the lights on in our collective, which is heavily dependent on income from event production.
The Aid EP additionally enables us to provide a bit of work for our mastering engineer, also a DJ and producer, financially impacted by event cancellations. All sales will be split 50/50 between the artists and ourselves, after mastering costs have been recouped.
Stay healthy out there – and if you have the means, we encourage you to find ways to reach out and support those affected in your local communities.